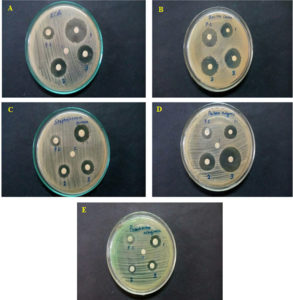

ISSN: 0973-7510
E-ISSN: 2581-690X
Often referred as the “jewel of the basin” the ocean contains a vast array of pivotal bioactive compounds from both living and non-living sources. The macroalgae have been regarded as a pool diversity of marine environment. They provide number of natural bioactive compounds to alleviate human ailments and thousands of them are isolated from distinct species and various places. Recently pharmacological industries paid attention to discovering various low side effect bioactive compounds from marine sources, especially macroalgae. The present study collected few red algae like Gelidiella acerosa (Forsskal), Acanthophora spicifera (Vahl) and Hypnea musciformis (Wulfen) from the low tide region in Pudumadam coast, Gulf of Mannar; Centroceras clavulatum (C. Agardh) and Gracillaria corticata (J. Agardh) from Pamban coast, Gulf of Mannar (GoM) and Galaxaura obtongata from Villunditirtham coast, Palk Bay and Laurencia papillosa (C. Agardh) (Greville) from the Olaikuda coastal region, Rameswaram, Palk Bay, Tamil Nadu, India and subjected for bioactive principles screening using various solvents as these compounds would be of a source for new drug candidates. Further, these seven methanol crude extracts examined for their anti-microbial potential using human pathogens. Our findings revealed stronger anti-microbial potential of methanol extracts of Gelidiella acerosa, Acanthophora spicifera and Hypnea musciformis. The results of the present study confirmed the potential use of marine algae as a reliable source of antibacterial agents. Based on these results, further purification, and identification of individual compounds required as they are specific for anti-microbial activity may pave way for the development of novel therapeutics to treat illness caused by microbes. Besides, further investigations are crucial to elucidate the structure and specific molecular mechanisms of these bioactive components which are responsible for various additional pharmacological activities.
Marine Compounds, Antimicrobial, Gelidiella Acerosa, Acanthophora spicifera, Hypnea musciformis
The marine environment is the jewel of treasury, a valuable and precious resource for diversity of natural products produced by aquatic organisms.1 Since marine derived bioactive compounds have unique chemical structures, pharmacological industries paid more attention to them due to their critical role in drug discovery and development.2 In fact, some of them are already under investigation to develop the new pharmaceutical lead compounds/agents2,3 against malaria, microbes, cancer, inflammation, microtubule, proliferation, hypertension and cytotoxic.4-9 In recent years, the list grows especially on discovering the low side effect drug leads or compounds.4 In line with this, hundreds of drug leads were identified and isolated from various marine sources, which include microorganisms, terrestrial plants, sponges, corals, macroalgae, molluscs, echinoderm, etc.10 The compounds isolated from various marine organisms are of variable chemicals in nature including peptides and phenols.11
In general, marine plants (marine macroalgae) are multicellular thallophytes and heterogeneous assemblage of photosynthetic eukaryotic organism.12 They are classically divided into three main divisions such as green (Chlorophytes), red (Rhodophytes) and brown algae (Phaeophytes).13 Macroalgae have evolved with an array of complex mechanisms for their survival and resist infections.14 These qualities make great potential for exploration of bioactive compounds against human illnesses. According to previous reports 3.5 percent extracts from marine origin exhibit toxicity against cancer cells.15 The isolation and separation of bioactive constituents from marine sources, especially algae, has received tremendous attention. This is due to their crucial role against various diseases like goiter, dysentery and diarrhea.16 Investigators around the world and pharmaceutical industry are trying to explore the novel mechanisms of many unexplored bioactive principles, especially peptides from marine macroalgae as drug leads or drug candidates.17 The following macroalgae such as Macrocysties, Laminaraia, Fucus, Sargassum, Gracillaria, Gelidiella, Hypnea, Turbinaria, Homorphysa and Hydrocultres are of potential interest.18
Besides, macroalgae are valuable sources of nutrient rich food ingredients and serving as a unique platform for new biologically functional compounds14 and minerals.19-23 Understanding the bio-regulatory function of various endogenous peptides in the organisms and their cellular mechanisms against specific cellular targets would be of promising strategy in drug lead or drug candidate development.24
Traditional uses of Macroalgae
For longer-term, macroalgae play crucial roles in the marine ecosystems not only in providing pharmaceutics, agricultural products, biofuels, nutrients, and skin protective care cosmetics,2,25,26 but also practiced in the Chinese, Korean and Japanese traditional medicine system.27-31
Habitat and diversity of macroalgae
There are 30,000 known species of macroalgae reported around the world under three major groups. Approximately 6500 species belonging to Rhodophyta, 1800 species of Phaeophyceae, and 1500 species of Chlorophyta.32,33 Of these, 145 species are directly used for nutrient purposes, and 24 species are used in complementary and alternative medicine. Besides, around 25 species utilized for cultivation, the preparation of animal feed and fertilizers, and 12 species planted and named as “marine farming”.34,35 India considered as one of the mega-biodiversity habitats for macroalgae and highly regarded as an endangered ecoregions in the world.36 Moreover, in the Indian coastal waters evidence with more diverged genera (i.e., 217) species (i.e., 844). Amongst the most abundant reported ones Rhodophyta with 434 species, next one is Chlorophyta with 216 species, and Phaeophyta with 191 species and finally Xanthophyte with 3 species.37 Whereas in the Tamil Nadu coastal regions (South India) inhabited more than 302 species of macroalgae. Nearly 147 species of marine macroalgae (i.e., 42 Chlorophyta, 31 Phaeophyceae, 69 Rhodophyta and 5 blue-green algae) are reported exclusively in the Gulf of Mannar.38 Besides, Gujarat coastal area have more than 202 species and the presence of macroalgae in other coastal areas of India such as Maharashtra, Andhra Pradesh, Goa and Lakshadweep Islands have 159, 79, 75 and 89 species respectively.39
Sources of bioactive peptides and other compounds
It is known that biologically active compounds are isolated not only from marine fauna but also from marine flora like macroalgae as potential therapeutics.17 Macroalgae contributes diverse types of peptides exhibiting various bioactive properties of Garg et al.40 bacteria and tumor. In fact, proteins like lectins and phycobiliproteins (PBP) of macroalgae substantiated for clinical diagnosis and other applications.41-43 Bioactive peptides like Ceratospongamide isolated from Rhodophyta, Ceratodictyon spongiosum and Sigmadocia symbiotica have shown anti-inflammatory properties44 and Kainoid compounds from Chondria armata perform a key role in neurophysiological syndromes like Alzheimer, Parkinson, and epilepsy recently used as standard therapeutic agent.45,46 In addition, some red algae have shown to reduce blood pressure and inhibit angiotensin-converting enzyme (ACE) activity.47-50 Similarly, some species of blue-green algae extracts are employed in complementary and alternative medicine for treating cardiovascular diseases.51,52 Table 1 describes a list of bio-potential properties of marine macroalgae found in Indian coastal waters.52 Many bioactive peptides from marine origin are under clinical trials.6,53 It is well established that microbial infection produces a huge rate of mortality in humans and aquatic organisms.54 In recent years, the usage of antibiotics increased significantly owing to various types of microbial infections and the pathogenic microbes becoming resistant to drugs is common due to indiscriminate use of antibiotics.55 It becomes a greater problem of giving proper treatment against resistant pathogenic organisms. In line with this, many researchers and pharmaceutical companies are showing keen interest in isolation of various peptides from red algae because of their easy cultivation with cheaper cost, low side effects and for their potency56 specifically on antimicrobial properties related to marine algae against several pathogens.57 Besides, marine algae represent an inexhaustible reservoir of raw materials used in pharmaceutical, medicine, food and cosmetics industries.58 Although various antimicrobial compounds derived from marine algae extracts consist of a diverse group of chemical constituents59 and they have exhibited antibacterial activity against microbes60,61 yet a limited data is available on red algae derived compounds/peptides from the Indian coastal waters specifically the Gulf of Mannar and Palk Bay Coasts, which encouraged the current investigation to collect, prepare the extract and identify bioactive peptides from the selected red algae of Gulf of Mannar regions (Figure 1) and examined antimicrobial properties of their crude extracts. Phytochemical screening and identification of bioactive constituents may help the drug discovery and development processes which include antimicrobial agents.
Table (1):
List of biopotential of macroalgae in Indian coastal regions
No. |
Name of the Species |
Activity |
|---|---|---|
1 |
Asparagopsis taxiformis |
Bio potential |
2 |
Gracillaria gracilis, G. edulis, Chondrococcus hornemanni, Caulerpa racemosa |
Anti-oxidant |
3 |
Ulva lactuca, Gracilaria corticata |
Anti-bacterial |
4 |
Anthophycus longifolius |
Anti-bacteria |
5 |
Kappaphycus alwarezi |
Anti-oxidant |
6 |
Laurencia obtus |
Phytochemical |
7 |
Ulva spp., Caulerpa spp., Spongomorpha spp. |
Anti-microbial |
8 |
Gracilaria sp. |
Anti-viral |
9 |
Sargassum wightii, Kappaphycus alwarezi |
Anti-microbial |
10 |
Green algae |
Anti-bacterial |
11 |
Sargassum wightii, Turbinara ornate |
Anti-bacterial |
12 |
Gracilaria corticata |
Anti-bacterial |
13 |
Gracilaria corticata |
Anti-microbial |
14 |
Falkenbergia hillebrandii |
Anti-bacterial |
15 |
Gracillaria sp., Padina sp., Sargassum sp. |
Anti-bacterial |
16 |
S. wightii |
Immunostimulation |
17 |
Kappaphycus alvarezii |
Anti-oxidant |
18 |
S. wightii |
Anti-oxidant |
19 |
Eucheuma denticulatum |
Anti-bacterial |
20 |
Gelidiella acerosa, Gracillaria verrucosa, Hypnea musciformis |
Anti-bacterial |
21 |
Ulva fasciata, H. musciformis |
Bio potential |
22 |
Laurencia sp. |
Anti-bacterial |
23 |
Spatoglossum variabile |
Bio potential |
24 |
Turbinaria spp. |
Anti-oxidant |
Study area
Gulf of Mannar (GoM) is the study area for this investigation; it is in the southern east coastal region of India; it is transitional zone between Arabian Sea and Indian Ocean. Palk Strait connects Gulf of Mannar with Bay of Bengal. (Figure 2). It is the first Marine Biosphere Reserve in Southeast Asia with the greatest marine biodiversity in the world and comprises of various marine components like mangroves, algal communities, seagrass beds, coral reefs, and salt marshes.62
Figure 2. Map of study area of Gulf of Mannar and Palk Bay Coast, Southeast Coast of India, International Maritime Boundary Line (IMBL)
IUCN-MMPATF.Gulf of Mannar and Palk Bay IMMA Factsheet. IUCN Joint SSC/WCPA Marine Mammal Protected Areas Task Force, 2022
Gulf of Mannar (Biologists paradise) has more than 3600 plant and animal species. The Gulf of Mannar’s diverse ecosystems support a widespread diversity of marine organisms including macroalgae: more than 147 species (Chlorophyta 42 species, Phaeophyceae 31 species, Rhodophyta 69 species and blue-green algae 5 species). This coastal region also contains other alga types like red and brown.63 Palk Bay and Gulf of Mannar separated by Mandapam peninsula and Rameswaram Island. There is only fringing reef found in the Palk Bay. So far, 117 species of corals reported in both regions, in which Palk Bay region alone contains more than 63 species of scleractinian corals.64,65
Sample collection
In the present investigation, macroalgae like Gelidiella acerosa,66 Acanthophora spicifera67 and Hypnea musciformis,68,69 were collected from low tide region in Pudumadam coast Centroceras clavulatum (C. Agardh) and Gracillaria corticata (J. Agardh) from Pamban coastal region of Gulf of Mannar), and Galaxaura oblongata from Villunditirtham coast, Palk Bay whereas Laurencia papillosa (C. Agardh) (Greville) was from Olaikuda coastal region, Rameswaram Palk Bay, southeast coast of India (Table 2). The collected macroalgae rinsed to remove epiphytes and other impurities and kept sterile in the laboratory located at Pudumadam, Ramanathapuram District, Tamil Nadu for taxonomy identification and for further experiments.70
Table 2. Classification of algae species
Classification |
Gelidiella Acerosa |
Acanthophora Spicifera |
Hypnea Musciformis |
|---|---|---|---|
Phylum: Rhodophyta Sub Phylum: Eurhodophytina Class: Florideophyceae Sub Class: Rhodymeniophycidae |
|||
Order: |
Gelidiales |
Ceramiales |
Gigartinales |
Family: |
Gelidellaceae |
Rhodomelaceae |
Cystocloniaceae |
Genus: |
Gelidiella |
Acanthophora |
Hypnea |
Species: |
acerosa |
spicifera |
musciformis |
Preparation of crude extract
The cleaned macroalgae allowed for shadow dry and powdered using mixer grinder. Ten (10) gm powder from each sample suspended in methanol (Merck AR Grade) and stored in a horizontal shaker (Remi) at room temperature and centrifuged to collect the supernatant and pooled. Methanol solvent extracts dried under nitrogen flow using a rotary vacuum evaporator (Puchi RII, Switzerland). To avoid degradation, concentrated pooled extract stored in sterile, airtight containers at -20 °C until further use.71,72
Bioactive compounds screening
Seven potential red algae extracts selected and subjected for bioactive principles screening. Mayer’s and Dragendorff’s tests employed alkaloids, terpenoids, tannins, and glycosides identification. In addition, the 1,1-diphenyl-2-picrylhydrazyl (DPPH) assay used to assess the phenolic content.73
Preparation of bacterial culture and anti-microbial evaluation
The bacterial strain individually inoculated in the test tube containing nutrient broth incubated at 28 ± 2 °C for 24 hrs. After that, the autoclaved Mueller-Hinton agar medium transferred aseptically into sterile Petri dish (approximately 20 mL per dish). Finally, the medium allowed to solidify. On this, the bacterial broth culture inoculated by using ‘L’ rod.
The crude extract which showed positive results on bioactive principles only evolved for the disc diffusion method as it is a qualitative and semi-quantitative test for determining antimicrobial susceptibility experiment. 74 The antibacterial (disc diffusion method) test performed on both Gram-positive and -negative bacteria using red algae crude extracts at different concentration between 6.5-25 µg/mL This method is used to follow pathogenic microorganisms: Escherichia coli, Staphylococcus aureus, Pseudomonas aeruginosa, Bacillus cereus, and Proteus vulgaris.74,75 The sterile disks individually soaked with crude extracts of each algal sample. Agar plates inoculated uniformly from the broth culture of tested microorganisms. The methanol crude extract of each algal species applied to a separate set of sterile disks using uniform inoculation of agar plates containing tested microorganisms. Streptomycin was employed as a positive control (PC) and methanol devoid of algae extract used as negative control (NC). The experiment runs duplicate, with clear radiance (zone formation).76 This study conducted on marine red algae for bioactive principles screening and for testing antimicrobial potential using crude extracts hence this study requires no ethical approval.
Statistical analysis
To validate data robustness and reproducibility, experiments conducted separately in triplicate. All data expressed as mean values ± SD, the mean values analyzed by three ways analysis of variance using the Statistical Analysis System (SAS) (1997) computer program.77
Red algae extract yield and phytochemical composition
This study used various solvents like polar (Ethanol, Methanol and Acetone) and non-polar (chloroform and hexane) for extract preparation. Amongst tested solvents methanol generated the maximum extract quantity which is sufficient for successive biological and phytochemical analyses. Table 3 summarizes the phytochemical screening results of the algae extracts, which display different compound profiles.
Table (3):
Phytochemical analysis of G. acerosa, A. spicifera and H. musciformis
Phytochemicals |
G. acerosa |
A. spicifera |
H. musciformis |
|---|---|---|---|
Tannins |
++ |
+++ |
– |
Alkaloids |
– |
– |
– |
Flavonoids |
+++ |
++ |
++ |
Saponins |
– |
– |
– |
Phytosterol |
+++ |
+++ |
– |
Glycoside |
+++ |
+++ |
+ |
Oils & Fats |
++ |
++ |
– |
Protein |
+++ |
+++ |
++ |
Carbohydrates |
+++ |
+++ |
+++ |
Resins |
++ |
++ |
– |
Coumarins |
++ |
++ |
+ |
Terpenoids |
+++ |
+++ |
– |
+ Weak (<3 µg/ml), ++ Moderate (5-7 µg/ml), +++ Strong (>8 µg/ml), – Absent
Anti-microbial activity evaluation
To determine whether the seaweed extracts had any inhibitory potential, screening was carried out using Pseudomonas aeruginosa, Escherichia coli, Staphylococcus aureus, Bacillus cereus and Proteus vulgaris by evaluating their growth potential in wells containing seaweed extract and bacterial suspension (extract concentrations ranging from 6.5, 12.5 and 25 µg/mL, respectively). Controls prepared containing broth and bacterial suspension (positive control), or broth only (negative control).
Anti-microbial activity of crude extract of Gracilaria corticata, Gelidiella acerosa, Galaxaura oblongata, Centroceras clavulatum, Laurencia papillosa, Hypnea musciformis and Acanthophora spicifera samples evaluated against five human pathogens by disk diffusion method. The Kirby-Bauer disk diffusion susceptibility test,78 generally employed to ascertain how sensitive or resistant pathogenic microorganisms are to various antimicrobial lead compounds.79 Out of seven red algae samples tested the following three species such as Gelidiella acerosa, Acanthophora spicifera and Hypnea musciformis only showed efficient activity (zone formation) against anti-microbial pathogens. However, the other methanol extracts of Gracilaria corticata, Galaxaura oblongata, Centroceras clavulatum and Laurencia papillosa showed less or no activity (negative result) (i.e., zone of inhibition not noticed) (Table 4 and Figure 3). Although, the present investigation used various extract concentrations ranging between 6.5, 12.5 of and 25 µmg/mL for the disc diffusion, the higher concentration (25 µmg/mL) has shown the good inhibitory zone, whereas the other lower concentrations exhibited less visible/no demarkable zone, hence this study adopted 25 µmg/mL as the only test concentration against bacterial strains.
Table (4):
Anti-microbial activity of seven species of red algae against bacterial pathogens
Bacterial strains |
G. acerosa |
G. corticata |
G. oblongata |
C. clavulatum |
L. papillosa |
A. spicifera |
H. musciformis |
|---|---|---|---|---|---|---|---|
E. coli |
++ |
– |
– |
– |
– |
++ |
++ |
B. cereus |
++ |
– |
– |
– |
– |
++ |
++ |
S. aureus |
++ |
– |
– |
– |
– |
++ |
++ |
P. vulgaris |
++ |
– |
– |
– |
– |
++ |
++ |
P. aeruginosa |
++ |
– |
– |
– |
– |
++ |
++ |
+ Activity; – No activity
Figure 3. Zone of inhibition against bacterial pathogens exposed to crude extracts of Gelidiella acerosa (1), Hypnea musciformis (2) and Acanthophora spicifera (3); PC – Postive Control. (A) Escherichia coli, (B) Bacillus cereus, (C) Staphylococcus aureus, (D) Proteus vulgaris, (E) Pseudomonas aeruginosa
The zone of inhibition against various bacterial pathogens by marine algae extracts from G. acerosa, A. spicifera and H. musciformis described in Table 5. The algae Gelidiella acerosa exhibited an inhibitory zone of 16 mm, 11 mm, 16 mm, 7 mm, and 11 mm against Escherichia coli, Staphylococcus aureus, Bacillus cereus, Pseudomonas acruginosa, and Proteus vulgaris, respectively but only 7 mm against P. aeruginosa. For Acanthophora spicifera, the zones of inhibition measured were 10 mm against Escherichia coli, 8 mm for Staphylococcus aureus, 22 mm for Bacillus cereus, and 13 mm for Proteus vulgaris, whereas the Hypnea musciformis exhibited 13 mm for Escherichia coli, 10 mm for Staphylococcus aureus, 26 mm for Bacillus cereus, and 20 mm for Proteus vulgaris. The zone of inhibition against Pseudomonas aeruginosa was very less in Acanthophora spicifera and H. musciformis, i.e. 2 mm and 5 mm, respectively. The above stated findings clearly showed that Gelidiella acerosa had the strongest activity against Bacillus cereus and Escherichia coli (i.e. 16 mm ZOI); whereas Acanthophora spicifera exhibited its activity against Bacillus cereus with the highest ZOI (22 mm) and Hypnea musciformis crude extract revealed the maximum ZOI (26 mm) against Bacillus cereus. To support further, the pre-evaluation of the anti-microbial activity of methanol extract (25 mg/mL) of Gelidiella acerosa, Acanthophora spicifera and Hypnea musciformis done against pathogenic bacteria shown in Table 6 and Figure 4.
Table (5):
Zone of inhibition by marine algae extracts from G. acerosa, A. spicifera and H. musciformis
No. |
Bacterial strains |
Algae |
Solvent |
NC |
PC |
Extract Conc (µg/mL) |
Zone of Inhibition (mm) |
|---|---|---|---|---|---|---|---|
1 |
E. coli |
G. acerosa, A. spicifera and H. musciformis |
M |
Nil |
0.4 |
25 |
161013 |
2 |
B. cereus |
G. acerosa, A. spicifera and H. musciformis |
M |
Nil |
1.0 |
25 |
162226 |
3 |
S. aureus |
G. acerosa, A. spicifera and H. musciformis |
M |
Nil |
0.3 |
25 |
11810 |
4 |
P. vulgaris |
G. acerosa, A. spicifera and H. musciformis |
M |
Nil |
0.3 |
25 |
111320 |
5 |
P. acruginosa |
G. acerosa, A. spicifera and H. musciformis |
M |
Nil |
0.3 |
25 |
725 |
NC: Negative Control (broth), PC: Positive Control (broth + bacteria suspension), M: Methanol
Table (6):
Pre-evaluation of the anti-microbial activity of methanol extract (25 µg/mL of each extract) of G. acerosa, A. spicifera and H. musciformis against pathogenic extracts against (Gram-positive) and (Gram-negative) bacteria
| No. | Bacterial strains | G. acerosa | A. spicifera | H. musciformis |
|---|---|---|---|---|
| % of bacterial viability ± SD | ||||
| 1 | Escherichia coli (Gram -) | 6.1 ± 2.4 | 5.9 ± 2.1 | 5.8 ± 1.7 |
| 2 | Bacillus cereus (Gram +) | 5.7 ± 2.5 | 5.1 ± 1.3 | 5.3 ± 1.9 |
| 3 | Staphylococcus aureus (Gram +) | 3.7 ± 1.3 | 2.9 ± 2.1 | 3.2 ± 1.8 |
| 4 | Proteus vulgaris (Gram -) | 3.2 ± 2.7 | 3.9 ± 2.1 | 3.7 ± 2.1 |
| 5 | Pseudomonas acruginosa (Gram -) | 6.4 ± 3.2 | 6.6 ± 2.7 | 6.0 ± 1.9 |
SD = Standard deviation
It is well known that bacterial infection causes high mortality among humans, animals, and aquatic organisms because many microorganisms like Bacillus subtilis which are accountable for foodborne gastroenteritis, Escherichia coli for mastitis and for many other harmful effects.80 Staphylococcus aureus causes abortion whereas Pseudomonas aeruginosa causes upper respiratory complications and fatal illness, while Salmonella sp. produces diarrhea and typhoid fever.81,82 The prevention/treatment of diseases dealt with many known drugs, chemicals or antibiotics however these pathogenic microorganisms become more resistant to these drugs indiscriminately.83 Moreover, antibiotic medications are becoming increasingly expensive and produce hypersensitivity for some and cause reduction in beneficial microorganisms in the gut and produce unfavorable effect on the host.84
Marine entities are rich sources of biologically active and structurally unique metabolites.85 Marine organisms capable of producing both primary and secondary metabolites, which are of interest to many pharmaceutical companies as drug leads/candidates.86 Numerous researchers are interested in developing new alternative bioactive principles with low cost but high efficiency against resistant pathogens.2,87-89 In fact, some of unique new therapeutic leads, natural products of marine origin with a variety of biological activities have been screened and isolated.90 In line with this, it has been demonstrated that the active components and different algae extracts have revealed antimicrobial activity against a variety of pathogens including bacteria.10
The disc diffusion method is a qualitative and semi-quantitative test adopted by many studies for determining antimicrobial susceptibility, predominantly employed in natural products research.91,92 The present study adopted this diffusion method to screen seven red algal species, which include Gelidiella acerosa, Acanthophora spicifera, Hypnea musciformis, Gracilaria corticata, Galaxaura oblongata, Centroceras clavulatum and Laurencia papillosa crude extracts to test their qualitative anti-microbial potential. The methanol extract of Gracilaria corticata, Galaxaura oblongata, Centroceras clavulatum and Laurencia papillosa samples were unable to exhibit anti-microbial impact on pathogenic microorganisms like as Pseudomonas acruginosa, Escherichia coli, Staphylococcus aureus, Bacillus cereus, and Proteus vulgaris while the remaining three species exhibited good antibacterial properties. The above results suggest that microbial pathogens are exhibiting mechanisms against resistance through intracellular drug accumulation, enzymatic inactivation, and modification of target sites and decrease and insufficient drug concentration.93,94
In line with previous investigations, the current study confirmed that the methanol extraction yields higher and showed effective anti-microbial activity than other organic solvents used.5 The use of methanol solvent extraction always provides higher efficiency and yielded anti-microbial compounds.5,95-98 To support further, the shade dried macroalgae extracts had privileged action on microbial pathogens than that of fresh macroalgae extracts99 as the extract obtained from fresh macroalgae samples exhibited lower anti-microbial activity.100
The present results obtained with methanol extracts of Gelidiella acerosa, Acanthophora spicifera and Hypnea musciformis collected from Gulf of Mannar coastal regions are comparable to those with different species collected from the Canary Islands against various bacteria.101 Further evidence suggest that the methanol-dichloromethane extracts of Hypnea musciformis from the Indian coast are more effective against pathogenic bacterial strains.102 In line with this, numerous reports are aligned and supported that the methanol extract of Gelidiella acerosa, Acanthophora spicifera as well as Hypnea musciformis exhibits strong antimicrobial potential against a variety of bacterial strains.102,103 Hence, the present study outcomes clearly indicate and confirm that the methanol extract of Gelidiella acerosa, Acanthophora spicifera and Hypnea musciformis have shown significant antimicrobial activity against bacterial strains.
The present investigation outcome with anti-microbial activities observed in crude methanol extracts of Gelidiella acerosa, Acanthophora spicifera and Hypnea musciformis gathered from Pudumadam, Gulf of Mannar, southeast coast of India provides an excellent indication that algae maintain an effective antimicrobial properties against Escherichia coli, Staphylococcus aureus, Bacillus cereus, Pseudomonas aeruginosa and Proteus vulgaris bacterial strains and this antibacterial effect may be due to the presence of various prospective natural compounds. The present study concludes that the red algae, Gelidiella acerosa, Acanthophora spicifera and Hypnea musciformis are potential sources of bioactive compounds that evoked strong antibacterial activities, which utilized for the development of various therapeutic agents including natural antibiotics against multidrug-resistant bacteria. However, further investigations required structural elucidation as well as specific molecular mechanisms of action which are responsible for various additional pharmacological activities. The characterization of various bioactive components obtained from these macroalgae may pave way for the development of more novel therapeutics by the pharmaceutics industry as they may contain unexplored health benefits, in addition to their previously well demonstrated nutritional blended in the Eastern as well as Western traditional cuisines. The adaptation of algal nutrition is now becoming a global trend in the human diet.
ACKNOWLEDGMENTS
None.
CONFLICT OF INTEREST
The authors declare that there is no conflict of interest.
AUTHORS’ CONTRIBUTION
CMR conceptualized the study and provided guidance. KDK performed experiments and analyzed. AAYA performed statistical analysis. EMMH, RYY and MAS wrote the manuscript. All authors read and approved the final manuscript for publication.
FUNDING
None.
DATA AVAILABILITY
All datasets generated or analyzed during this study are included in the manuscript.
ETHICS STATEMENT
Not applicable.
- Rogers AD, Appiah-Madson H, Ardron JA, et al. Accelerating ocean species discovery and laying the foundations for the future of marine biodiversity research and monitoring. Front Mar Sci. 2023;10:1224471.
Crossref - Seyed MA, Ayesha S. Marine-derived pipeline anticancer natural products: a review of their pharmacotherapeutic potential and molecular mechanisms. Futur J Pharm Sci. 2021;7(1):203.
Crossref - Martins RM, Nedel F, Guimaraes VBS, et al. Macroalgae Extracts From Antarctica Have Antimicrobial and Anticancer Potential. Front Microbiol. 2018;9:412.
Crossref - Carpena M, Garcia-Perez P, Garcia-Oliveira P, et al.Biological properties and potential of compounds extracted from red seaweeds. Phytochemistry Reviews, 2022;22(6):1509-1540.
Crossref - Avila-Romero M, María García-Bores A, Garduño-Solorzano G, et al. Antimicrobial activity of some macroalgae of the Veracruzano Reef System (SAV), Mexico. Saudi J Biol Sci. 2023; 30(1):103496.
Crossref - Aneiros A, Garateix A. Bioactive peptides from marine sources:Pharmacological properties and isolation procedures. J Chromatogr B Analyt Technol Biomed Life Sci. 2004;803(1):41-53.
Crossref - Bhatnagar I, Kim SK. Immense essence of excellence: marine microbial bioactive compounds. Marine Drugs. 2010;8(10):2673-2701.
Crossref - Wijesekara I, Kim S. Angiotensin-I-converting enzyme (ACE) inhibitors from marine resources:Prospects in the pharmaceutical industry. Marine Drugs. 2010;8(4):1080-1093.
Crossref - Wilson-Sanchez G, Moreno-Felix C, Velazquez C, et al. Anti-mutagenicity and anti-proliferative studies of lipidic extracts from white shrimp (Litopenaeus vannamei). Marine Drugs, 2010;8(11):2795-2809.
Crossref - Ely R, Supriya T, Naik CG. Antimicrobial activity of marine organisms collected off the coast of southeast India. J Exp Marine Biol Ecol. 2004;309(1):121-127.
Crossref - Jimeno J, Faircloth G, Soussa-Faro JF, Scheuer P, Rinehart K. New marine derived anticancer therapeutics-A journey from the sea to clinical trials. Marine Drugs. 2004;2(1):14-29.
Crossref - Pereira L. Macroalgae. Encyclopedia. 2021;1(1):177-188.
Crossref - Brodie J, Lewis J. (Eds.). Unravelling the algae: the past, present, and future of algal systematics (1st ed.). CRC Press. 2007.
Crossref - Silva A, Silva SA, Carpena M, et al. Macroalgae as a Source of Valuable Antimicrobial Compounds:Extraction and Applications. Antibiotics (Basel). 2020;25;9(10):642.
Crossref - Xudong Ma, Chunfu Wu, Wei Wang, Xiaobo Li Peptides from Plants: A New Source for Antitumor Drug Research. Asian J Trad Med. 2006;1. https://www.researchgate.net/publication/228583852
- Fan X, Bai L, Zhu L, Yang L, Zhang X. Marine algae-derived bioactive peptides for human nutrition and health. J Agric Food Chem. 2014;62(38):9211-22.
Crossref - Negreanu-Pirjol BS, Negreanu-Pirjol T, Popoviciu DR, Anton RE, Prelipcean AM. Marine Bioactive Compounds Derived from Macroalgae as New Potential Players in Drug Delivery Systems:A Review. Pharmaceutics. 2022;14(9):1781.
Crossref - Tuaputty H, Papilaya PM, Tuapattinaya P, Parry C, Alimudi S. Macroalgae As a Source of Food And Health For Coastal Communities in Moluccas Province. BIOEDUPAT:Pattimura Journal of Biology and Learning. 2024;4(1):153-164.
Crossref - Lichota A, Gwozdzinski K. Anticancer Activity of Natural Compounds from Plant and Marine Environment. Int J Mol Sci. 2018;19(11):3533.
Crossref - Bakus GJ, Targett NM, Schulte B. Chemical ecology of marine organisms: An overview. J Chem Ecol. 1986;12(5):951-987.
Crossref - Guiry MD, Guiry GM, Morrison L, et al. AlgaeBase: an on-line resource for algae. Cryptogamie Algologie. 2014;35(2):105-115.
Crossref - Conrad LS, Stacy C, Mikhail D, et al. NCBI Taxonomy: a comprehensive update on curation, resources and tools. Database, 2020; baaa062.
Crossref - Mayakrishnan V, Priya K, Noorlidah A, Ahmed ABA. Cardioprotective activity of polysaccharides derived from marine algae: An overview. Trends Food Sci Technol. 2013;30(2):98-104.
Crossref - Wang L, Wang N, Zhang W, et al. Therapeutic peptides: current applications and future directions. Sig Transduct Target Ther. 2022;7(1):48.
Crossref - Gao K, McKinley KR. Use of macroalgae for marine biomass production and CO2 remediation: a review. J Appl Phycol. 1994;6:45-60.
Crossref - 26Oren A, Gunde-Cimerman N. Mycosporines and mycosporine-like amino acids:UV protectants or multipurpose secondary metabolites? FEMS Microbiol Lett. 2007;269(1):1-10.
Crossref - Sun K, Wu L, Wang S, Deng W. Antitumor effects of Chinese herbal medicine compounds and their nano-formulations on regulating the immune system microenvironment. Front Oncol. 2022: 949332.
Crossref - Liu T, Li Q, Xu X, Li G, Tian C, Zhang T. Molecular mechanisms of anti-cancer bioactivities of seaweed polysaccharides. Chin Herb Med. 2022;14(4):528-534.
Crossref - Xiang Y, Guo Z, Zhu P, Chen J, Huang Y. Traditional Chinese medicine as a cancer treatment:Modern perspectives of ancient but advanced science. Cancer Med. 2019;8(5):1958-1975.
Crossref - Moon S, Kim J. Iodine content of human milk and dietary iodine intake of Korean lactating mothers. Int J Food Sci Nutr. 1999;50(3):165-171.
Crossref - Pei-Gen X, Shan-Lin F. Traditional antiparasitic drugs in China. Parasitol Today. 1986;2(112):353-355.
Crossref - Guiry MD. How many species of algae are there? A reprise. Four kingdoms, 14 phyla, 63 classes and still growing. Journal of Phycology, 2024; 60:214-228.
Crossref - Guiry MD. How many species of algae are there? J Phycol. 2012;48(5):1057-1063.
Crossref - Zemke-White WL, Ohno M. World Seaweed Utilisation:An End-of-Century Summary. J Appl Phycol. 1999;11(4):369-376.
Crossref - Pereira H, Barreira L, Figueiredo F, et al. Polyunsaturated Fatty Acids of Marine Macroalgae: Potential for Nutritional and Pharmaceutical Applications. Marine Drugs. 2012;10(9):1920-1935.
Crossref - Myers N, Mittermeier RA, Mittermeier CG, Da Fonseca GAB, Kent J. Biodiversity hotspots for conservation priorities. Nature. 2000;403(6772):853-858.
Crossref - Harikrishnan M, Saipriya PP, Prakash P, C. Jayabaskaran, Sarita G. Bhat, Multi-functional bioactive secondary metabolites derived from endophytic fungi of marine algal origin. Curr Res Microb Sci. 2021;2:100037.
Crossref - Ramesh CH, Prasastha VR, Shunmugaraj T, et al. Diversity and impacts of macroalgae and cyanobacteria on multi-stressed coral reefs in the Gulf of Mannar Marine Biosphere Reserve. Mar Environ Res. 2023;191:106161.
Crossref - Venkataraman K, Raghunathan C. Coastal and marine biodiversity of India. In: Venkataraman K, Sivaperuman C, eds. Marine Faunal Diversity in India. Amsterdam, Netherlands: Elsevier; 2015:303-348.
Crossref - Garg HS, Sharma M, Bhakuni DS, Pramanik BN, Bose AK. An antiviral sphingosine derivative from the green alga Ulva fasciata. Tetrahedron Lett. 1992;33(12):1641-1644.
Crossref - Calvete JJ, Costa FHF, Saker-SampaioS, et al. The amino acid sequence of the agglutinin isolated from red marine algae Bryothamnion triquetrum defines a novel lectin structure. Cell Mol Life Sci. 2000;57(2):343-350.
Crossref - Hori K, Ikegami S, Miyazawa K, Ito K. Mitogenic and antineoplastic isoagglutinins from the red algae Solieria robusta. Phytochemistry. 1988;27(7):2063- 2070.
Crossref - Ennamany R, Saboureau D, Mekideche N. Creppy. EE. SECMA 1®, a mitogenic hexapeptide from Ulva algae modulates the production of proteoglycans and glycosaminoglycans in human foreskin fibroblast. Hum Exp Toxicol. 1998;17(1):18-22.
Crossref - Tan LT, Williamson RT, Gerwick WH, Watts KS, McGough K, Jacobs R. cis,cis- and trans,trans-Ceratospongamide, New Bioactive Cyclic Heptapeptides from the Indonesian Red Alga Ceratodictyon spongiosum and Symbiotic Sponge Sigmadocia symbiotica. j Org Che. 2000;65(2):419-425.
Crossref - Higa T, Kuniyoshi M. Toxins associated with medicinal and edible seaweeds. J Toxicol Toxin Rev. 2000;19(2):119-137.
Crossref - Smit AJ. Medicinal and pharmaceutical uses of seaweed natural products:a review. J Appl Phycol. 2004;16(4):245-262.
Crossref - Suetsuna K. Purification and identification of angiotensin I converting enzyme inhibitors from the red alga Porphyra yezoensis. J Marine Biotechnol. 1998a;6(3):163-167.
- Suetsuna K. Separation and identification of angiotensin Iconverting enzyme inhibitory peptides from peptic digest of Hizikia fusiformis protein. Nippon Suisan Gakkaishi. 1998;64(5):862-866.
- Suetsuna K, Maekawa K, Chen JR. Antihypertensive effects of Undaria pinnatifida (wakame) peptide on blood pressure in spontaneously hypertensive rats. J Nutr Biochem. 2004;15(5):267-272.
Crossref - Sato M, Hosokawa T, Yamaguchi T, et al. Angiotensin Iconverting enzyme inhibitory peptides derived from wakame (Undaria pinnatifida) and their antihypertensive effect in spontaneously hypertensive rats. J Agric Food Chem. 2002;50(21):6245-6252.
Crossref - Yeh GY, Davis RB, Phillips RS. Use of complementary therapies in patients with cardiovascular disease. Am J Cardiol. 2006;98(5):673-680.
Crossref - Nahin RL, Barnes PM, Stussman BJ, Bloom B. Costs of complementary and alternative medicine (CAM) and frequency of visits to CAM practitioners: United States, 2007. Natl Health Stat Report. 2009;(18):1-14.
- Xu WJ, Liao XJ, Xu SH, et al. Isolation, structure determination, and synthesis of galaxamide, a rare cytotoxic cyclic pentapeptide from a marine algae Galaxaura filamentosa. Organic Letter. 2008;10(20):4569-4572.
Crossref - Kandhasamy M, Arunachalam KD. Evaluation of in vitro antibacterial property of seaweeds of southeast coast of India. Afr J Biotechnol. 2008;7(12):1958-1961.
- Lavanya R, Veerappan N. Antibacterial Potential of Six Seaweeds Collected from Gulf of Mannar of the Southeast Coast of India. Adv Biol Res. 2011;5:38-44.
- Wani HM, Chen CW, Huang CY, et al. Development of Bioactive Peptides Derived from Red Algae for Dermal Care Applications:Recent Advances. Sustainability. 2023;15(11):8506.
Crossref - Siddhanta AK, Mody KH, Ramavat BK, et al. Bioactivity of marine organisms:Part VIII – Screening of some marine flora of western coast of India. Indian J Exp Biol. 1997;36(6):638-643.
- Badea V, Balaban DP, Rapeanu G, Amariei C, Maria C, Badea CF. The antibacterial activity evaluation of Cystoseira barbata biomass and some agents upon bacteria from oropharyngeal cavity. Romanian. Soc Biol Sci. 2009;14(6):4851-4857.
- Afifah SN, Darah I, Far SS, Nordi MKMJ, Aili ZN. Antimicrobial Activity of Various Extracts of a Tropical Chlorophyta Macroalgae, Halimeda discoidea. Journal of Applied Sciences. 2010;10(23):3007-3013.
Crossref - Lima-Filho JVM, Carvalho AFFU, Freitas SM, Melo VMM. Antibacterial activity of extracts of six macroalgae from the northeastern brazilian coast. Braz J Microbiol. 2002;33(4).
Crossref - Paul G, Yusuf S, Sharma S. Unmasking of the Brugada syndrome phenotype during the acute phase of amiodarone infusion. Circulation. 2006;114(11):489-491.
Crossref - United Nations Development Programme (UNDP) Annual Report 2008.https://www.undp.org/publications/undp-annual-report-2008
- Gupta K, Manchikanti P. Coastal and marine biological diversity conservation in India: challenges in implementation. Biodivers Conserv.2025;34: 2977–2998.
Crossref - Pillai CSG. Composition of the coral fauna of the southern coast of India and the Laccadives. Zool. Soc. Lond. 1971a;28:301-321.
- Pillai CSG. Recent corals from the southeast Coast of Inda. PSBR James (Ed.). recent advances in Marine Biology. Today and Tommorrow s Printers and pub., New Delhi. 1986;107-204.
- Heike KL. Marine biodiversity conservation. Current Biology, 2021;31(19);R1190-R1195
Crossref - Vandepitte L, Vanhoorne B, Decock W, et al. A decade of the World Register of Marine Species – General insights and experiences from the Data Management Team: Where are we, what have we learned and how can we continue? PLoS ONE. 2018;13(4):e0194599.
Crossref - Cleland EE. Biodiversity and Ecosystem Stability. Nature Education Knowledge 2011;3(10):14
- Yokoya NS, Nauer F, Oliveira MC. Concise review of the genus Hypnea J.V.Lamouroux, 1813. J Appl Phycol. 2020;32(6):3585-3603.
Crossref - Manisseri MK, Antony G, Rao GS. Common Seaweeds and Seagrasses of India: Herbarium. Vol 1. Kochi, India: Central Marine Fisheries Research Institute (CMFRI); 2012
- Celikler S, Sibel T, Ozgur V, Sedef ZA, Gamze Y, Rahmi B. Anti hyperglycemic and antigenotoxic potential of Ulva rigida ethanolic extract in the experimental diabetes mellitus. Food Chem Toxicol. 2009;47(8)1837-1840.
Crossref - Ramakritinan CM, Durai Kannu K, Muthuraj V, Sornalatha N. MAA-Palythine Compound of Three Red (Macro) Algae: Gelidiella acerosa, Acanthophora spicifera and Hypnea musciformis of Gulf of Mannar, Southeast Coast of India. Int J Curr Microbiol App Sci. 2017;6(7):607-615.
Crossref - Jaber SA. The antioxidant and anticancer activity of Quercus coccifera plant leaves extracts. Saudi J Biol Sci. 2024;31(5):103979.
Crossref - Sreenivasa Rao P, Parekh KS. Antibacterial activity of Indian seaweed extracts. Botanica Marina, 1981;24(11):577-582.
Crossref - El-masry AH, Fahmy HH, Ali Abdelwahed SH. Synthesis and Antimicrobial Activity of Some New Benzimidazole Derivatives. Molecules. 2000; 5(12):1429-1438.
Crossref - Mohamed SN, Ranwa AE, Emad AG, El-Shoubaky GA, Nehal AHK, Osman Shark Reef’s untapped seaweed resources: Chemical characterization and bioactive potentials of Digenea simplex and Padina pavonica from the Egyptian Red Sea, South African Journal of Botany. 2026; 188: 151-164.
Crossref - Ali Z, Bhaskar SB. Basic statistical tools in research and data analysis. Indian J Anaesth. 2016; 60(9):662–669.
Crossref - Patel JB, Tenover FC, Turnidge JD, Jorgensen JH. Susceptibility test methods: dilution and disk diffusion methods. In: Versalovic J, Carroll KC, Funke G, Jorgensen JH, Landry ML, Warnock DW, eds. Manual of Clinical Microbiology. 10th ed. Washington, DC: ASM Press; 2011:1122-1143.
Crossref - Clinical Laboratory Standards Institute. Performance standards for antimicrobial disk susceptibility tests;Approved standard 9th ed. CLSI document M2-A9. Clinical Laboratory Standards Institute, Wayne, PA. 2006;26:1.
- Elbehiry A, Abalkhail A, Marzouk E, et al. An Overview of the Public Health Challenges in Diagnosing and Controlling Human Foodborne Pathogens. Vaccines (Basel). 2023;11(4):725.
Crossref - Levine MM. Escherichia coli that cause diarrhea: enterotoxigenic, enteropathogenic, enteroinvasive, enterohemorrhagic, and enteroadherent. J Infect Dis. 1987; 155(3):377-89.
Crossref - Al-Kobaisi MF. Jawetz, Melnick, Adelberg’s Medical Microbiology: 24th Edition. Sultan Qaboos Univ Med J. 2007;7(3):273–275.
- Sieradzki K, Robert RB, Haber SW, Tomasz A. The development of vanomycin resistance in patient with Methicillin-Resistant Staphylococcus aureus Infection. N Engl J Med. 1999;340(7):517-523.
Crossref - Idsoe O, Guthe T, Willcox RR, de Weck AL. Nature and extent of penicillin side-reactions, with particular reference to fatalities from anaphylactic shock. Bull World Health Organ. 1968;38:159-188.
- Macedo MWFS, Da Cunha NB, Carneiro JA, et al. Marine organisms as a rich source of biologically active peptides. Frontiers in Marine Science. 2021;8.
Crossref - Smith P, Hiney MP, Samuelsen OB. Bacterial resistance to antimicrobial agents used in fish farming: A critical evaluation of method and meaning. Annual Review of Fish Diseases. 1994;4:273-313.
Crossref - Vaou N, Stavropoulou E, Voidarou C, Tsigalou C, Bezirtzoglou E. Towards Advances in Medicinal Plant Antimicrobial Activity:A Review Study on Challenges and Future Perspectives. Microorganisms. 2021;9(10):2041.
Crossref - Ahmad M, Tahir M, Hong Z, et al. Plant and marine-derived natural products:sustainable pathways for future drug discovery and therapeutic development. Front Pharmacol. 2025;15:1497668.
Crossref - Rubiño S, Peteiro C, Aymerich T, Hortós M. Brown Macroalgae (Phaeophyceae): A Valuable Reservoir of Antimicrobial Compounds on Northern Coast of Spain. Marine Drugs. 2022; 20(12):775.
Crossref - Bansemir A, Blume M, Schroder S, Lindequist U. Screening of cultivated seaweeds for antibacterial activity against fish pathogenic bacteria. Aquaculture. 2006;252(1):79-84.
Crossref - Rajasulochana P, Dhamotharan R, Krishnamoorthy P, Murugesan S. Antibacterial activity of the extracts of marine red and brown algae. J Am Sci. 2009;5(3):20-25.
- Schwarz S, Noble WC. Aspects of bacterial resistance to antimicrobials used in veterinary dermatological practice. Vet Dermatol. 1999;10(3):163-176.
Crossref - Temesgen AB, Shiferaw SA. Antimicrobial Multidrug Resistance and Mechanisms of Action: An Overview. Biomed Res Int. 2025;2025:8847267.
Crossref - Rosell KG, Srivastava LM. Fatty acids as antimicrobial substances in brown algae. Hydrobiology. 1987;151:471-475.
Crossref - Sastry VMVS, Rao GRK. Antibacterial substances from marine algae:successive extraction using benzene, chloroform and methanol. Botanica Marina, 1994;37(4):357-360.
- Paul VJ, Puglisi MP. Chemical mediation of interactions among marine organisms. Natural Product Reports. 2004;21(1):189.
Crossref - Sasidharan S, Darah I, Noordin MKMJ. Screening antimicrobial activity of various extract of Gracilaria changii, Pharmaceutical Biology, 2009;47(1):72-76.
Crossref - Rao PSP, Sreenivasa Rao P, Karmarkar SM. Antibacterial substances from brown algae. II. Efficiency of solvent in the evaluation of antibacterial substances from Sargassum johnstonni Setchelet Gardner. Botanica Marina. 1986;29:503-507.
- Khotimchenko SV, Vaskovsky VE. Distribution of C20 polyenoic fatty acids in red macrophytic algae. Botanica Marina, 1990;33(6):525-52.
- Val A, Platas G, Basilio A, et al. Screening of antimicrobial activities in red, green and brown macroalgae from Gran Canaria (Canary Islands, Spain). Int Microbiol. 2001;4(1):35-40.
Crossref - Selvin J, Lipton AP. Biopotentials of Ulva fasciata and Hypnea musciformis collected from the Peninsular Coast of India. J Marine Sci Technol. 2004;12(1):1-6.
Crossref - Reichelt JL, Borowitzka MA. Antimicrobial activity of marine algae: Results of a large-scale screening program. Hydrobiologia, 1984;116:158- 168.
Crossref - Mahasneh I, Jamal M, Case Shneh M, Zibdeh M. Antibiotic activity of marine algae against multi antibiotic resistant bacteria. Microbes. 1995;83(334):23-26.
© The Author(s) 2026. Open Access. This article is distributed under the terms of the Creative Commons Attribution 4.0 International License which permits unrestricted use, sharing, distribution, and reproduction in any medium, provided you give appropriate credit to the original author(s) and the source, provide a link to the Creative Commons license, and indicate if changes were made.